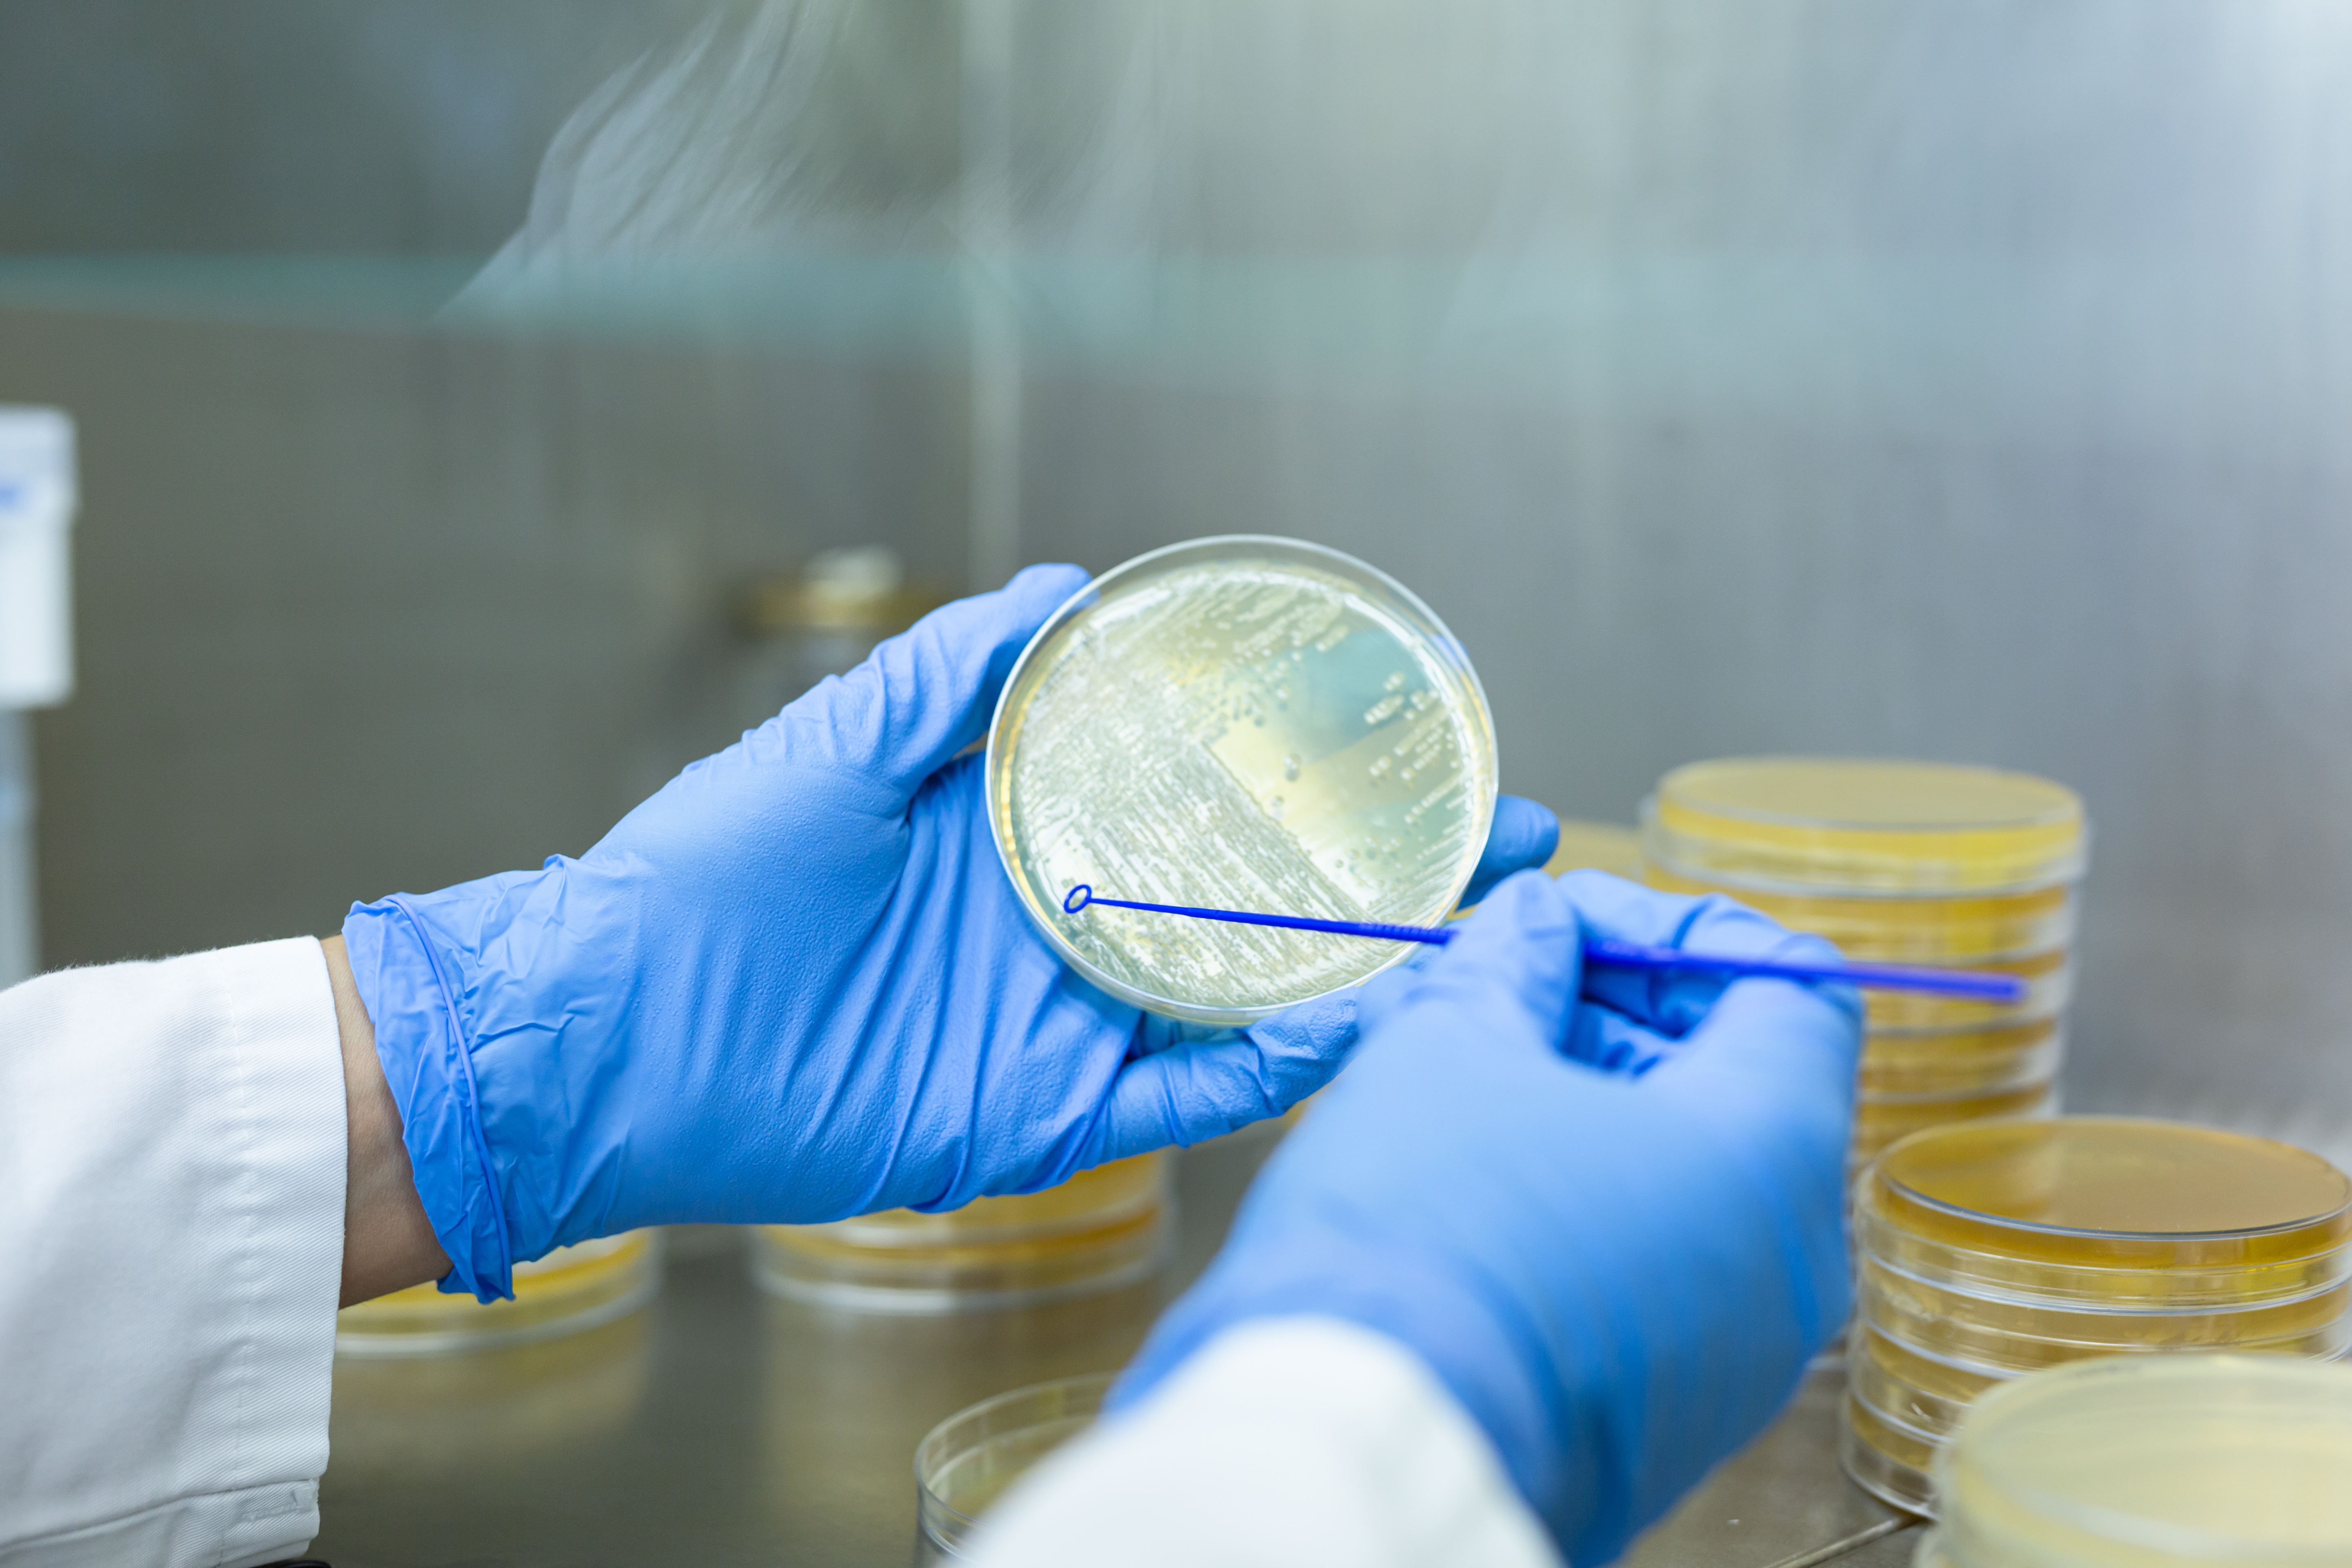

Topambtenaar: 'Ja, er komt nieuw voedselbeleid'
Sinds afgelopen najaar heeft Nederland weer een minister van Landbouw, Natuur en Voedselbeleid: boerendochter Carola Schouten van de Christenunie. Marjolijn Sonnema, directeur-generaal Agro en Natuur bij het ministerie van LNV lichtte een tipje van de sluier op wat voedingssector van de bewindsvrouw kan verwachten, zo bleek tijdens de nieuwjaarsbijeenkomst van adviesbureau Schuttelaar & Partners.